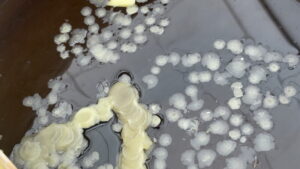

อ่างทอง ส่องตัวเลขน้ำตาเทียนในโอ่งงานพิธีไหว้ครูอาจารย์สรณ์ ท่ามกลางบรรยากาศอัศจรรย์ เข้มขลังด้วยมนต์และพลังเวทย์ มีลูกศิษย์ของขึ้นองค์ลงซึ่งเป็นความเชื่อส่วนบุคคล
อ่างทอง ส่องตัวเลขน้ำตาเทียนในโอ่งงานพิธีไหว้ครูอาจารย์สรณ์ ท่ามกลางบรรยากาศอัศจรรย์ เข้มขลังด้วยมนต์และพลังเวทย์ มีลูกศิษย์ของขึ้นองค์ลงซึ่งเป็นความเชื่อส่วนบุคคล
วันที่ 27 เม.ย. 69 ที่บริเวณสำนักสักยนันต์ อ.สรณ์ สมิงคเวทย์ ส.คงเวทย์ เลขที่ 4 หมู่ที่ 10 ตำบลสีบัวทอง อำเภอแสวงหา จังหวัดอ่างทอง อาจารย์ สรณ์ สมิงคเวทย์ ได้จัดพิธีไหว้ครูและครอบเศียรครูประจำปี โดยมีลูกศิษย์เข้าร่วมพิธีจำนวนมาก ผู้ที่มาร่วมงานไม่พลาดต้องมาส่องน้ำตาเทียนในโอ่งน้ำมนต์ พบเป็น 87 ไปเสี่ยงดวง ซึ่งเป็นพิธีที่ศักดิ์สิทธิ์ เข้มขลังด้วยมนต์ ซึ่งระหว่างทำพิธีได้มีลูกศิษย์ของขึ้น องค์ลง จำนวนมาก ซึ่งเป็นความเชื่อส่วนบุคคล

กนกศักดิ์ แสงตระการ / อ่างทอง / 0819221669

